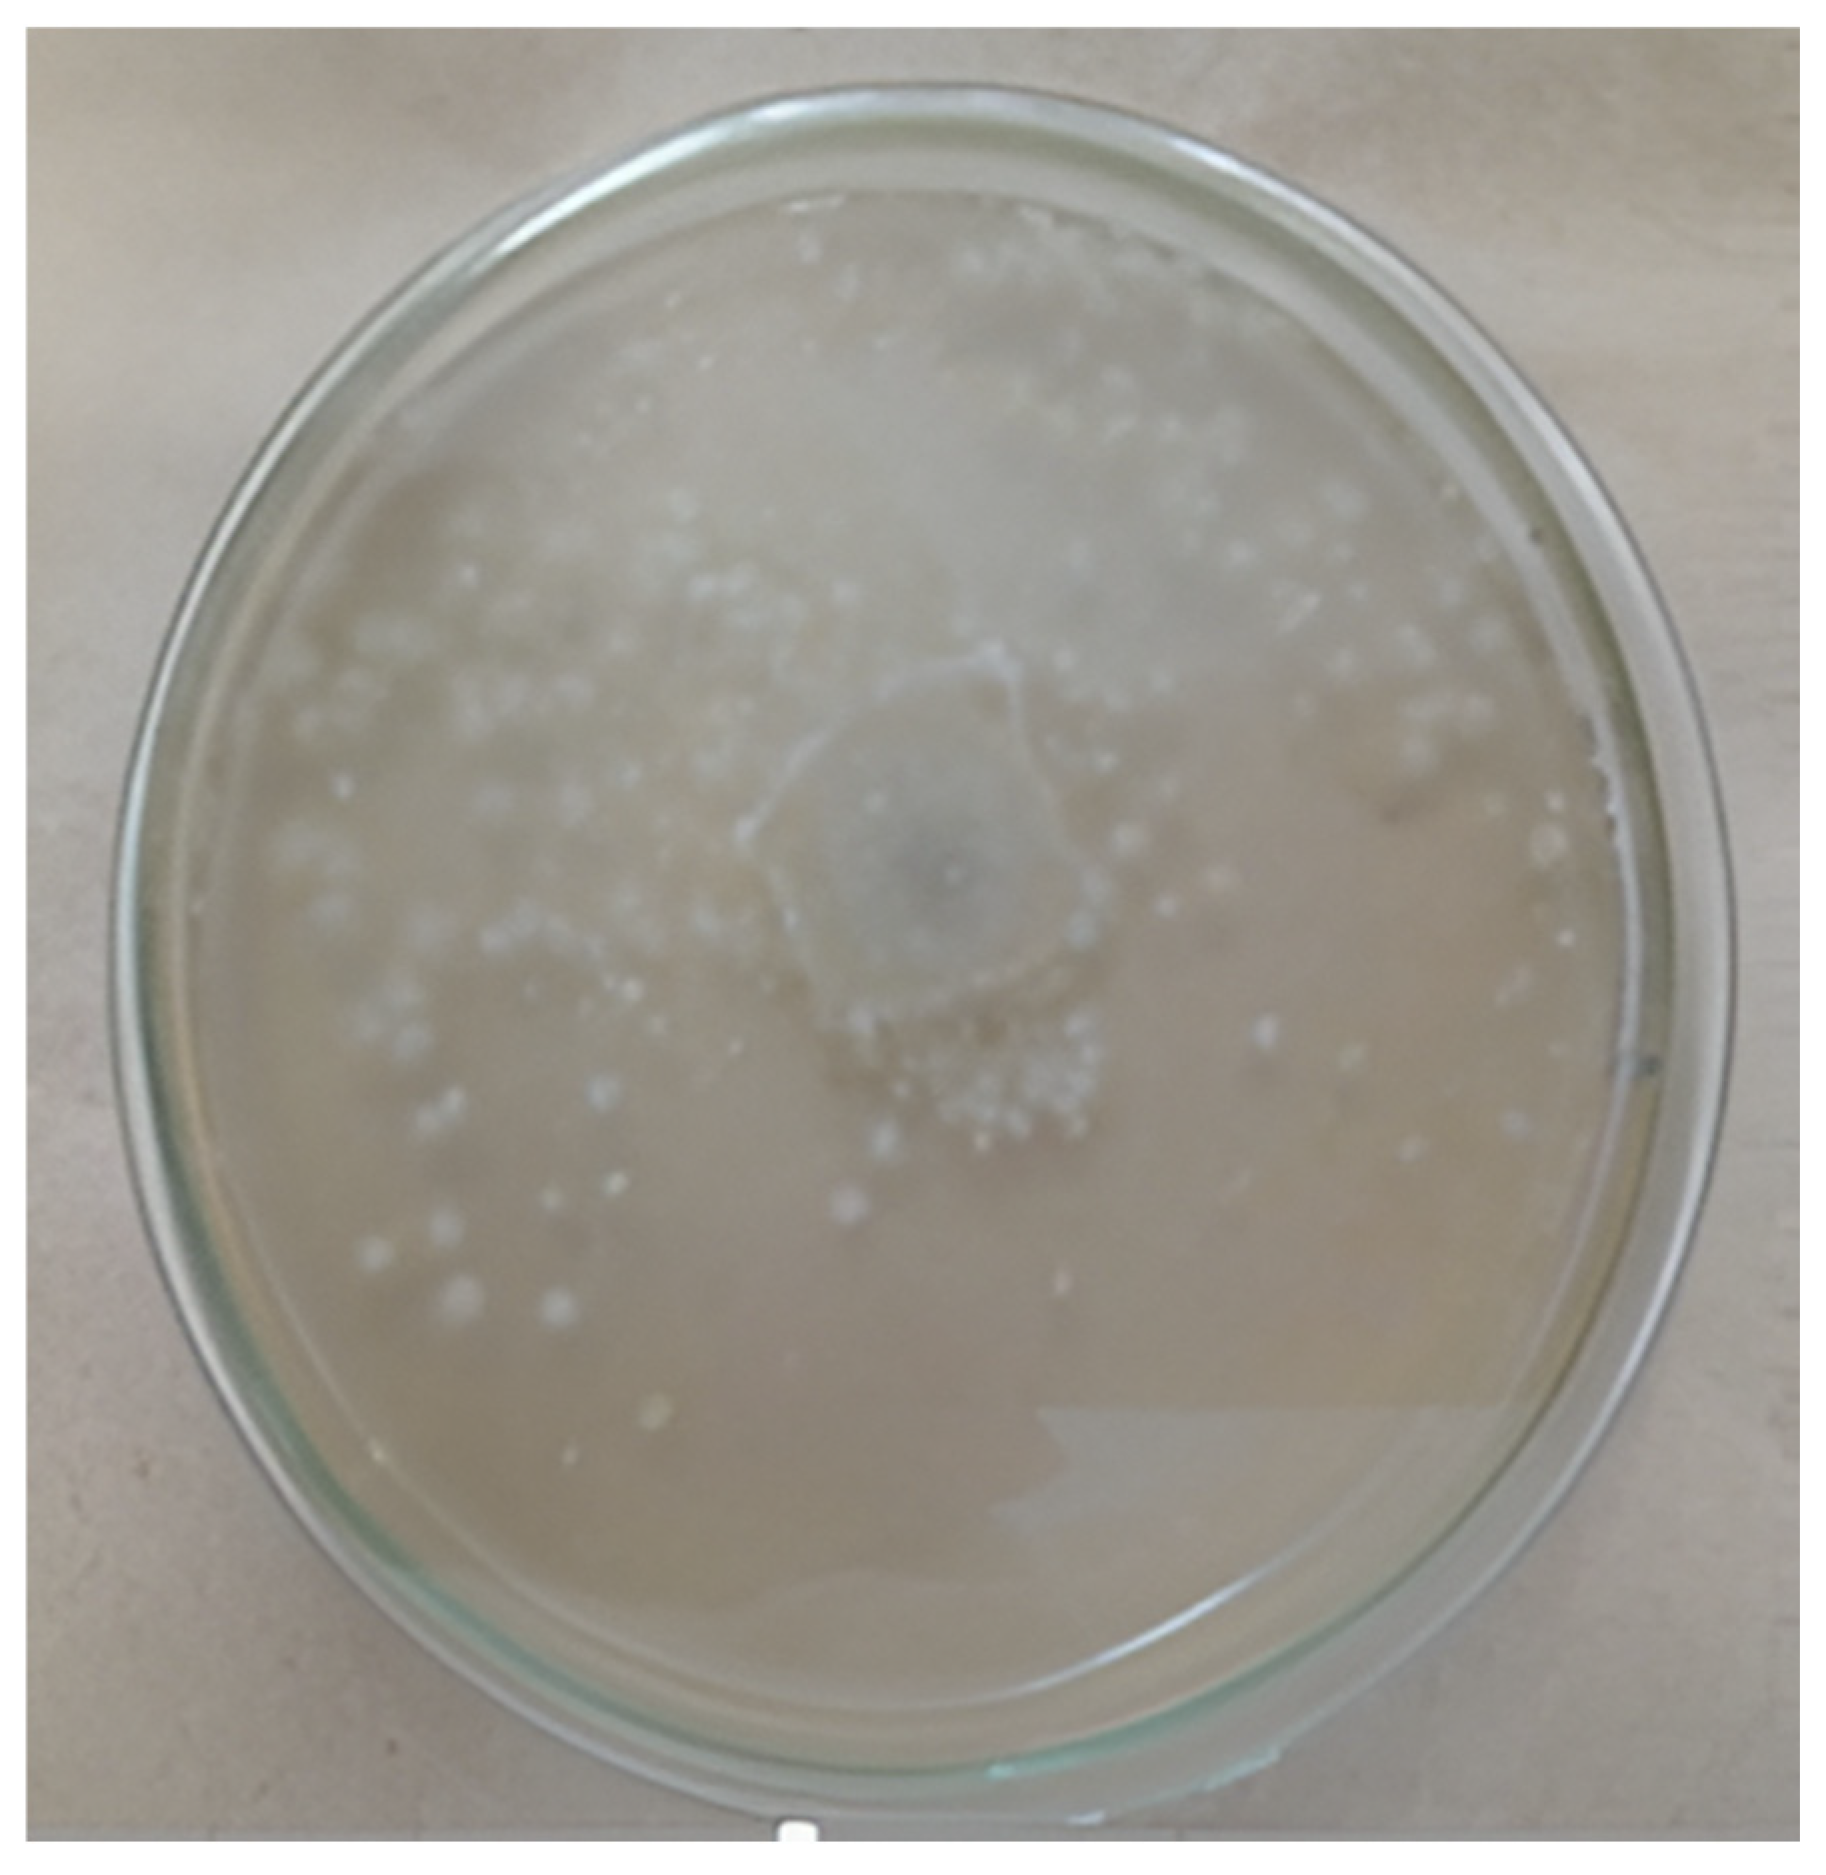
Diversity 17 00546 g005 Diversity 17 00546 g005

Soil Fungal Activity and Microbial Response to Wildfire in a Dry Tropical Forest of Northern Colombia
Abstract
1. Introduction
2. Materials and Methods
2.1. Description of the Study Area
2.2. Soil Sampling
2.3. Physicochemical Characterization
2.4. Microbial Respiration
2.5. Mineralized Nitrogen
2.6. Biological Diversity Estimates
2.7. Diversity Indexes
2.8. Statistical Analysis
3. Results
3.1. Physicochemical Characterization
3.2. Microbial Respiration and Mineralized Nitrogen
3.3. Fungal Diversity: Identification of Aspergillus Morphotypes
3.4. Spearman’s Correlation
3.5. PCA and CA
3.6. Diversity Indexes
4. Discussion
Addressing Post-Fire Fungal Dynamics: Ecological and Methodological Considerations
5. Methodological Considerations and Future Research
6. Conclusions
Author Contributions
Funding
Institutional Review Board Statement
Data Availability Statement
Acknowledgments
Conflicts of Interest
Abbreviations
| ACE | Abundance Coverage Estimator |
| AD | Apparent Density |
| CA | Correspondence Analysis |
| BTBNR | Banco Totumo Bijibana Natural Reserve |
| CEC | Cation Exchange Capacity |
| CFU | Colony Forming Units |
| C/N | Carbon/Nitrogen |
| D | Simpson Index |
| EC | Electrical Conductivity |
| H | Shannon–Weaver Index |
| N | Nitrogen |
| Nm | Mineralized Nitrogen |
| OC | Organic Carbon |
| OM | Organic Matter |
| PCA | Principal Component Analysis |
| % | Percentage |
| meq 100 g−1 | Cation Exchange Capacity in Milli-Equivalents Per 100 g of Soil |
References
- Jezierska-Tys, S.; Wesołowska, S.; Gałązka, A.; Joniec, J.; Bednarz, J.; Cierpiała, R. Biological activity and functional diversity in soil in different cultivation systems. Int. J. Environ. Sci. Technol. 2020, 17, 4189–4204. [Google Scholar] [CrossRef]
- Gardi, C.; Jeffery, S.; Saltelli, A. An estimate of potential threat levels to soil biodiversity in the EU. Glob. Change Biol. 2013, 19, 1538–1548. [Google Scholar] [CrossRef] [PubMed]
- Zenteno-Rojas, A.; Martínez-Romero, E.; Castañeda-Valbuena, D.; Rincón-Molina, C.; Ruíz-Valdiviezo, V.M.; Meza-Gordillo, R.; Rincón-Rosales, R. Structure and diversity of native bacterial communities in soils contaminated with polychlorinated biphenyls. AMB Express 2020, 10, 124. [Google Scholar] [CrossRef] [PubMed]
- Gouda, S.; Nayak, S.; Bishwakarma, S.; Kerry, R.G.; Das, G.; Patra, J.K. Role of microbial technology in agricultural sustainability. In Microbial Biotechnology: Applications in Agriculture and Environment; Patra, J.K., Vishnuprasad, C.N., Das, G., Eds.; Springer: Singapore, 2017; pp. 181–202. [Google Scholar] [CrossRef]
- Shao, T.; Zhao, J.J.; Liu, A.; Long, X.; Rengel, Z. Effects of soil physicochemical properties on microbial communities in different ecological niches in coastal area. Appl. Soil Ecol. 2020, 150, 103486. [Google Scholar] [CrossRef]
- Arias, M.; González-Pérez, J.A.; González-Vila, F.J.; Ball, A.S. Soil health—A new challenge for microbiologists and chemists. Int. J. Microbiol. 2005, 8, 13–21. [Google Scholar] [CrossRef][Green Version]
- Jhariya, M.K.; Singh, L. Herbaceous diversity and biomass under different fire regimes in a seasonally dry forest ecosystem. Environ. Dev. Sustain. 2021, 23, 6800–6818. [Google Scholar] [CrossRef]
- Jhariya, M.K.; Singh, L. Effect of fire severity on soil properties in a seasonally dry forest ecosystem of Central India. Int. J. Environ. Sci. Technol. 2021, 18, 3967–3978. [Google Scholar] [CrossRef]
- Socarrás, A. Mesofauna edáfica: Indicador biológico de la calidad del suelo. Pastos Forrajes 2013, 36, 5–13. Available online: http://scielo.sld.cu/scielo.php?script=sci_arttext&pid=S0864-03942013000100001 (accessed on 30 June 2024).
- Mommer, L.; Kirkegaard, J.; Ruijven, J. Root–root interactions: Towards a rhizosphere framework. Trends Plant Sci. 2016, 21, 209–217. [Google Scholar] [CrossRef] [PubMed]
- Thakrey, M.; Singh, L.; Jhariya, M.K.; Tomar, A.; Singh, A.K.; Toppo, S. Impact of disturbance on biomass, carbon, nitrogen storage in vegetation and soil properties in tropical dry deciduous forest in Chhattisgarh, India. Land Degrad. Dev. 2022, 33, 1810–1820. [Google Scholar] [CrossRef]
- Manral, V.; Bargali, K.; Bargali, S.S.; Jhariya, M.K.; Padalia, K. Relationships between soil and microbial biomass properties and annual flux of nutrients in Central Himalayan forests, India. Land Degrad. Dev. 2022, 33, 2014–2025. [Google Scholar] [CrossRef]
- Martínez, J.M.; Galantini, J.A.; Duval, M.E. Contribution of nitrogen mineralization indices, labile organic matter, and soil properties in predicting nitrogen mineralization. J. Soil Sci. Plant Nutr. 2018, 18, 73–89. [Google Scholar] [CrossRef]
- Martínez-Mera, E.; García-Paredes, J.D.; Corrales-Paternina, A.; Torregroza-Espinosa, A.C. Variability of nitrogen mineralization from organic matter in agricultural soils in the north of Colombia. Chiang Mai Univ. J. Nat. Sci. 2021, 20, e2021073. [Google Scholar] [CrossRef]
- Verma, S.; Jayakumar, S. Impact of forest fire on physical, chemical, and biological properties of soil: A review. Proc. Int. Acad. Ecol. Environ. Sci. 2012, 2, 168–176. Available online: http://www.iaees.org/publications/journals/piaees/articles/2012-2(3)/impact-of-forest-fire.pdf (accessed on 30 June 2024).
- Gómez, E.; Conti, M.E.; Pioli, R.N.; Bisaro, V. Evaluación de poblaciones bacterianas, fúngicas y su diversidad, en un suelo vértico bajo vegetación natural, en sistemas degradados y en recuperación. Rev. Fac. Agron. 2000, 20, 83–89. Available online: https://core.ac.uk/download/pdf/144233833.pdf (accessed on 15 June 2024).
- Vallejo, V.; Roldan, F.; Dick, R. Soil enzymatic activities and microbial biomass in an integrated agroforestry chronosequence compared to monoculture and a native forest of Colombia. Biol. Fertil. Soil 2010, 46, 577–587. [Google Scholar] [CrossRef]
- Martínez-Mera, E.; Torregroza-Espinosa, A.C.; Crissien-Borrero, T.J.; Marrugo-Negrete, J.L.; González-Márquez, L.C. Evaluation of contaminants in agricultural soils in an Irrigation District in Colombia. Heliyon 2019, 5, e02217. [Google Scholar] [CrossRef]
- Weather Spark. El Clima de Repelón, Atlántico. Available online: https://es.weatherspark.com (accessed on 10 March 2024).
- Pizano, C.; Gonzáles, R.; García, H.; Isaacs, P.; Gonzáles, M.; Piñeros, P.; Ramírez, W. Bosques Secos Tropicales en Colombia; Instituto de Investigación de Recursos Biológicos Alexander Von Humboldt: Bogotá, Colombia, 2014; Available online: http://repository.humboldt.org.co/handle/20.500.11761/9333 (accessed on 15 June 2024).
- Pinzón, L.F.; De León, E.M.; Campo, M.; Tarazona, H.; Soto, M.C. Conociendo y Conservando el DRMI Banco Totumo Bijibana; Concesión Costera Cartagena-Barranquilla, S.A.S.: Barranquilla, Colombia; Fundación Omacha: Bogotá, Colombia; Corporación Autónoma Regional del Atlántico: Barranquilla, Colombia; Ecoex-plora Consultoría: Barranquilla, Colombia, 2020; Available online: https://www.ecoexploraconsultoria.com/wp-content/uploads/2021/03/Libro-Bijibana.pdf (accessed on 10 March 2024).
- IGAC-Instituto Geográfico Agustín Codazzi. Métodos Analíticos del Laboratorio de Suelos, 6th ed.; Imprenta Nacional de Colombia: Bogotá, Colombia, 2006.
- NTC 5264–Norma Técnica Colombiana. Calidad del Suelo. Determinación del pH; Editorial ICONTEC: Bogotá, Colombia, 2008. [Google Scholar]
- NTC 5350–Norma Técnica Colombiana. Calidad de Suelo. Determinación de Fósforo Disponible; Editorial ICONTEC: Bogotá, Colombia, 2014. [Google Scholar]
- Castellanos, J.Z. Manual de Interpretación de Análisis de Suelos y Aguas, 2nd ed.; Intagri: Celaya, México, 2000. [Google Scholar]
- NTC 5268–Norma Técnica Colombiana. Calidad de Suelo. Determinación de la Capacidad de Intercambio Catiónico; Editorial ICONTEC: Bogotá, Colombia, 2014. [Google Scholar]
- Stotzky, G. Microbial respiration. In Agronomy Monographs; Norman, A.G., Ed.; American Society of Agronomy: Madison, WI, USA, 1965; Volume 13, pp. 1550–1572. [Google Scholar] [CrossRef]
- Guerrero-Ortiz, P.L.; Quintero-Lizaola, R.; Espinoza-Hernández, V.; Benedicto-Valdés, G.S.; Sánchez-Colín, M.D. Respiración de CO2 como indicador de la actividad microbiana en abonos orgánicos de Lupinus. Terra Latinoam. 2012, 30, 352–362. Available online: https://www.scielo.org.mx/scielo.php?script=sci_arttext&pid=S0187-57792012000400355 (accessed on 24 April 2024).
- Woods End Research. Guide to Solvita Testing and Managing Your Soil; Woods End Research Laboratory, Inc.: Mt. Vernon, ON, Canada, 1997. [Google Scholar]
- Rawls, J.W. Estimating soil bulk density from particle size analysis and organic matter content. Soil Sci. 1983, 135, 123–125. [Google Scholar] [CrossRef]
- Castellanos, J.Z.; Cueto, J.A.; Macías, J.; Salinas, J.R.; Tapia, L.M.; Cortes, J.M.; González, I.J.; Mata, H.; Mora, M.; Vásquez, A.; et al. La Fertilización de los Cultivos de Maíz, Sorgo y Trigo en México; INIFAP: Celaya, México, 2005. Available online: https://www.intagri.com/public_files/Manual%20de%20fertilizacion.pdf (accessed on 15 June 2024).
- Watanabe, T. Soil and Seed Fungi; CRC Press: Boca Raton, FL, USA, 2010. [Google Scholar]
- Villareal, H.; Álvarez, M.; Córdoba, S.; Escobar, F.; Fagua, G.; Gast, F.; Mendoza, H.; Ospina, M.; Umaña, A. Manual de Métodos para el Desarrollo de Inventarios de Biodiversidad; Instituto de Investigación de Recursos Biológicos Alexander Von Humboldt: Bogotá, Colombia, 2004; Available online: http://repository.humboldt.org.co/bitstream/handle/20.500.11761/31419/63.pdf (accessed on 24 April 2024).
- Escalante-Espinosa, T. ¿Cuántas especies hay? Los estimadores no paramétricos de Chao. Elementos 2003, 52, 53–56. Available online: https://www.redalyc.org/pdf/294/29405209.pdf (accessed on 24 April 2024).
- R Core Team. R: A Language and Environment for Statistical Computing; R Foundation for Statistical Computing: Vienna, Austria, 2018. [Google Scholar]
- Hammer, Ø.; Harper, D.; Ryan, P. PAST: Paleontological Statistics Software Package for Education and Data Analysis. Palaeontol. Electron. 2001, 4, 1–9. Available online: https://palaeo-electronica.org/2001_1/past/past.pdf (accessed on 24 April 2024).
- Alvarez-Garreton, C.; Boisier, J.P.; Garreaud, R.; González, J.; Rondanelli, R.; Gayó, E.; Zambrano-Bigiarini, M. HESS Opinions: The unsustainable use of groundwater conceals a ‘Day Zero’. Hydrol. Earth Syst. Sci. 2024, 28, 1605–1616. [Google Scholar] [CrossRef]
- Maroto, E.; Rogel, J. Aplicación de sistemas de biorremediación de suelos y aguas contaminadas por hidrocarburos. Geocisa 2004, 4, 297–305. [Google Scholar]
- Rodelo-Torrente, S.; Torregroza-Espinosa, A.C.; Moreno-Pallares, M.; Pinto-Osorio, D.; Corrales-Paternina, A.; Echeverría-González, A. Soil fertility in agricultural production units of tropical areas. Glob. J. Environ. Sci. Manag. 2022, 8, 403–418. [Google Scholar] [CrossRef]
- Sadeghian, S. La acidez del suelo: Una limitante común para la producción de café. Av. Técnicos 2016, 466, 1–12. Available online: https://biblioteca.cenicafe.org/bitstream/10778/704/1/avt0466.pdf (accessed on 24 June 2024).
- Artiola, J.F.; Crimmins, M.A.; Musil, S.A.; Walworth, J.L. Soil and land pollution. Environ. Sci. Pollut. Res. 2019, 219, 219–235. [Google Scholar] [CrossRef]
- Havlin, J.L.; Tisdale, S.L.; Nelson, W.L.; Beaton, J.D. Soil Fertility and Fertilizers: An Introduction to Nutrient Management, 8th ed.; Pearson: Upper Saddle River, NJ, USA, 2013. [Google Scholar]
- Andrades, M.; Martínez, E. Fertilidad del Suelo y Parámetros que la Definen, 3rd ed.; Universidad de la Rioja Servicio de Publicaciones: La Rioja, Spain, 2014. [Google Scholar]
- Jhariya, M.K. Vegetation ecology and carbon sequestration potential of shrubs in the tropics of Chhattisgarh, India. Environ. Monit. Assess. 2017, 189, 518. [Google Scholar] [CrossRef]
- Jhariya, M.K. Influences of forest fire on forest floor and litterfall dynamics in Boardmen Wildlife Sanctuary (C.G.), India. J. For. Environ. Sci. 2017, 33, 330–341. [Google Scholar] [CrossRef]
- Wang, J.; Chen, C.; Ye, Z.; Li, J.; Feng, Y.; Lu, Q. Relationships between fungal and plant communities differ between desert and grassland in a typical dryland region of northwest China. Front. Microbiol. 2018, 9, 2327. [Google Scholar] [CrossRef]
- Vellozas, T.; Púa, M.; Mello, E.D.; Cardozo, J. Incendios Forestales y su Afectación al Medio Ambiente, Prevención y Combate. Instituto Militar de Estudios Superiores Escuela de Ingeniería Militar. 2010. Available online: https://docplayer.es/58449082-Incendios-forestales-y-su-afectacion-al-medio-ambiente-prevencion-y-combate.html (accessed on 10 March 2024).
- Dawson, C.J.; Hilton, J. Fertilizer availability in a resource-limited world: Production and recycling of nitrogen and phosphorus. Food Policy 2011, 36, 14–22. [Google Scholar] [CrossRef]
- Raj, A.; Jhariya, M.K. Site quality and vegetation biomass in the tropical Sal mixed deciduous forest of Central India. Landsc. Ecol. Eng. 2021, 17, 387–399. [Google Scholar] [CrossRef]
- Raj, A.; Jhariya, M.K. Carbon storage, flux and mitigation potential of tropical Sal mixed deciduous forest ecosystem in Chhattisgarh, India. J. Environ. Manag. 2021, 293, 112829. [Google Scholar] [CrossRef] [PubMed]
- Mohanty, R.B.; Panda, T. Soil respiration and microbial population in a tropical deciduous forest soil of Orissa, India. Flora 2011, 206, 1040–1044. [Google Scholar] [CrossRef]
- Mataix-Solera, J.; Cerdà, A.; Arcenegui, V.; Jordán, A.; Zavala, L. Fire effects on soil aggregation: A review. Earth Sci. Rev. 2011, 109, 44–60. [Google Scholar] [CrossRef]
- Alster, C.J.; van de Laar, A.; Goodrich, J.P. Quantifying thermal adaptation of soil microbial respiration. Nat Commun 2023, 14, 5459. [Google Scholar] [CrossRef] [PubMed]
- Allam, A.; Borsali, A.H.; Kefifa, A.; Zouidi, M.; Gros, R. Effect of fires on certain properties of forest soils in western Algeria. Acta Technol. Agric. 2020, 23, 111–117. [Google Scholar] [CrossRef]
- Holden, S.R.; Treseder, K.K. A meta-analysis of soil microbial biomass responses to forest disturbances. Front. Microbiol. 2013, 4, 163. [Google Scholar] [CrossRef]
- Ford, D.; Cookson, W.; Adams, M.A.; Grierson, P. Role of soil drying in nitrogen mineralization and microbial community function in semi-arid grasslands of North-West Australia. Soil Biol. Biochem. 2007, 39, 1557–1569. [Google Scholar] [CrossRef]
- Celaya, H.; Castellanos, A. Mineralización de nitrógeno en el suelo de zonas áridas y semiáridas. Terra Latinoam. 2011, 29, 343–356. Available online: https://www.scielo.org.mx/scielo.php?script=sci_arttext&pid=S0187-57792011000300343 (accessed on 24 June 2024).
- Monsalve, O.I.; Gutiérrez, J.S.; Cardona, W.A. Factores que intervienen en el proceso de mineralización de nitrógeno cuando son aplicadas enmiendas orgánicas al suelo: Una revisión. Rev. Colomb. Cienc. Hortícolas 2017, 11, 200–209. Available online: https://core.ac.uk/download/pdf/217560483.pdf (accessed on 24 June 2024). [CrossRef]
- Martínez-Mera, E.; Torregroza-Espinosa, A.C.; Valencia-García, A.; Rojas-Jerónimo, L. Relationship between soil physicochemical characteristics and nitrogen-fixing bacteria in agricultural soils of the Atlántico department, Colombia. Soil Environ. 2017, 36, 174–181. Available online: http://www.se.org.pk/Papers.aspx?issueid=77 (accessed on 30 July 2024). [CrossRef]
- Romero, M.; Inés, M.; Reinoso, E.; Moreno, A. Wild soil fungi able to degrade the herbicide isoproturon. Rev. Mex. Micol. 2008, 29, 1–7. Available online: https://www.scielo.org.mx/scielo.php?script=sci_arttext&pid=S0187-31802009000100002 (accessed on 24 June 2024).
- Op De Beeck, M.; Troein, C.; Siregar, S.; Gentile, L.; Abbondanza, G.; Peterson, C.; Persson, P.; Tunlid, A. Regulation of fungal decomposition at single-cell level. ISME J. 2020, 14, 896–905. [Google Scholar] [CrossRef] [PubMed]
- Chao, A.; Chiu, C.H. Species richness: Estimation and comparison. In Wiley StatsRef: Statistics Reference Online; John Wiley & Sons, Ltd.: Hoboken, NJ, USA, 2016; pp. 1–26. [Google Scholar] [CrossRef]
- Stinca, A.; Ravo, M.; Marzaioli, R.; Marchese, G.; Cordella, A.; Rutigliano, F.A.; Esposito, A. Changes in Multi-Level Biodiversity and Soil Features in a Burned Beech Forest in the Southern Italian Coastal Mountain. Forests 2020, 11, 983. [Google Scholar] [CrossRef]
- Guerrero, C.; Mataix-Solera, J.; Gómez, I.; García-Orenes, F.; Jordán, M.M. Microbial recolonization and chemical changes in a soil heated at different temperatures. Int. J. Wildl. Fire 2005, 14, 385–400. [Google Scholar] [CrossRef]
- Mataix-Solera, J.; Navarro-Pedreño, J.; Guerrero, C.; Gómez, I.; Marco, B.; Mataix, J. Effects of an experimental fire on soil microbial populations in a Mediterranean environment. In Man and Soil at the Third Millennium; Rubio, J.L., Morgan, R.P.C., Asins, S., Andreu, V., Eds.; Geoforma Ediciones: Logroño, Spain, 2002. [Google Scholar]
- Aprile, F.; Lorandi, R. Evaluation of Cation Exchange Capacity (CEC) in Tropical Soils Using Four Different Analytical Methods. J. Agric. Sci. 2012, 4. [Google Scholar] [CrossRef]
- Browik, A.; Wyszkowska, J. Soil moisture as a factor affecting the microbiological and biochemical activity of soil. Plant Soil Environ. 2016, 62, 250–255. [Google Scholar] [CrossRef]
- Arias-Mota, R.M.; Lagunes-Reyes, M.; García-Pérez, J.A.; De la Cruz-Elizondo, Y. Interacción entre cepas de hongos solubilizadores de fósforo y diferentes fuentes de nitrógeno sobre la solubilización y mineralización de fósforo. Alianzas y Tendencias BUAP 2020, 5, 1–19. Available online: https://www.aytbuap.mx/publicaciones#h.6d3xqupfu8t9 (accessed on 21 March 2025).
- Nardoto, G.B.; Bustamante, M.M. Effects of fire on soil nitrogen dynamics and microbial biomass in savannas of Central Brazil. Pesq. Agropec. Bras. 2003, 38, 955–962. [Google Scholar] [CrossRef]
- Vásquez, J.R.; Macias, F.; Menjivar, J.C. Respiración del suelo según su uso y su relación con algunas formas de carbono en el Departamento del Magdalena, Colombia. Bioagro 2013, 25, 175–180. [Google Scholar]
- Zaitsev, A.S.; Gongalsky, K.B.; Malmström, A.; Persson, T.; Bengtsson, J. Why are forest fires generally neglected in soil fauna research? A mini-review. Appl. Soil Ecol. 2016, 98, 261–271. [Google Scholar] [CrossRef]
- Habai-Masunga, R.; Nwakaego-Uzokwe, V.; Deusdedit-Mlay, P.; Odeh, I.; Singh, A.; Buchan, D.; De Nevee, S. Nitrogen mineralization dynamics of different valuable organic amendments commonly used in agriculture. Appl. Soil Ecol. 2016, 101, 185–193. [Google Scholar] [CrossRef]
- Stolpovsky, K.; Gharasoo, M.; Thullner, M. The impact of pore-size heterogeneities on the spatiotemporal variation of microbial metabolic activity in porous media. Soil Sci. 2012, 177, 98–110. [Google Scholar] [CrossRef]

| Soil Respiration (kg C ha−1 d−1) | Class | Soil Status |
|---|---|---|
| 0 | No soil activity | Inert soil without biological activity |
| <10.64 | Low soil activity | The soil lacks available OM |
| 10.64–17.92 | Medium to moderately low soil activity | Soil has lost OM, and its activity is low |
| 17.92–35.84 | Medium soil activity | Soil is approaching or declining from an ideal state of biological activity |
| 35.84–71.68 | Ideal soil activity | Ideal status of soil |
| >71.68 | Unusually high soil activity | Very high soil activity and high %OM |
| Soil Sample | M ± DE (%) | pH ± DE | Text | OM ± DE (%) | P ± DE (mg kg−1) | N ± DE (%) | CEC ± DE (meq 100 g−1) | EC ± DE (dS m−1) |
|---|---|---|---|---|---|---|---|---|
| 1 | 33.9 ± 0.23 | 5.76 ± 0.12 | FA | 2.30 ± 0.18 | 71.3 ± 16.1 | 0.114 ± 0.009 | 58.6 ± 13.2 | 0.50 ± 0.05 |
| 2 | 32.6 ± 0.39 | 5.60 ± 0.13 | FL | 2.16 ± 0.20 | 68.8 ± 5.32 | 0.107 ± 0.009 | 53.5 ± 2.61 | 0.87 ± 0.04 |
| 3 | 31.5 ± 2.07 | 5.46 ± 0.19 | L | 0.03 ± 0.001 | 70.7 ± 17.0 | 0.002 ± 0.001 | 51.2 ± 6.06 | 0.82 ± 0.04 |
| 4 | 32.6 ± 0.55 | 5.90 ± 0.41 | FL | 0.11 ± 0.07 | 51.6 ± 4.18 | 0.005 ± 0.003 | 51.1 ± 5.24 | 0.86 ± 0.19 |
| 5 | 33.4 ± 0.56 | 6.19 ± 0.22 | FL | 0.31 ± 0.07 | 43.4 ± 8.06 | 0.015 ± 0.003 | 50.9 ± 0.70 | 0.98 ± 0.12 |
| 6 | 36.7 ± 8.92 | 6.25 ± 0.12 | FL | 0.78 ± 0.08 | 47.6 ± 11.0 | 0.039 ± 0.003 | 63.5 ± 10.9 | 0.84 ± 0.04 |
| 7 | 28.3 ± 0.28 | 6.00 ± 0.14 | L | 0.50 ± 0.09 | 61.5 ± 10.0 | 0.025 ± 0.004 | 56.7 ± 21.6 | 0.79 ± 0.09 |
| 8 | 31.8 ± 1.28 | 5.18 ± 0.27 | L | 0.23 ± 0.02 | 56.1 ± 1.42 | 0.011 ± 0.000 | 64.7 ± 30.5 | 0.77 ± 0.10 |
| 9 | 34.3 ± 1.14 | 5.58 ± 0.07 | FL | 0.17 ± 0.13 | 45.9 ± 13.4 | 0.008 ± 0.006 | 44.2 ± 2.23 | 1.01 ± 0.06 |
| 10 | 34.6 ± 0.45 | 4.96 ± 0.15 | FL | 0.28 ± 0.09 | 67.2 ± 0.27 | 0.013 ± 0.004 | 58.2 ± 10.7 | 0.68 ± 0.07 |
| 11 | 34.2 ± 0.33 | 5.10 ± 0.11 | FL | 1.65 ± 0.05 | 48.0 ± 17.7 | 0.082 ± 0.002 | 46.1 ± 2.85 | 0.90 ± 0.11 |
| 12 | 43.4 ± 2.70 | 5.93 ± 0.13 | FL | 1.34 ± 0.05 | 75.8 ± 2.54 | 0.066 ± 0.002 | 67.1 ± 4.21 | 0.63 ± 0.15 |
| 13 | 42.5 ± 0.64 | 6.34 ± 0.18 | FL | 0.46 ± 0.07 | 72.5 ± 4.80 | 0.023 ± 0.003 | 66.5 ± 13.0 | 0.74 ± 0.20 |
| 14 | 41.2 ± 2.47 | 6.30 ± 0.13 | FL | 0.30 ± 0.04 | 51.8 ± 19.2 | 0.014 ± 0.002 | 67.9 ± 13.8 | 0.77 ± 0.04 |
| 15 | 34.9 ± 0.52 | 6.57 ± 0.07 | FL | 0.79 ± 0.08 | 73.0 ± 19.3 | 0.039 ± 0.004 | 56.2 ± 18.2 | 0.71 ± 0.15 |
| 16 | 31.0 ± 0.95 | 6.26 ± 0.12 | FL | 0.58 ± 0.11 | 67.3 ± 13.1 | 0.029 ± 0.005 | 69.2 ± 5.42 | 0.56 ± 0.24 |
| 17 | 26.4 ± 3.60 | 6.61 ± 0.04 | FL | 0.51 ± 0.09 | 87.3 ± 1.09 | 0.025 ± 0.004 | 52.7 ± 17.0 | 0.66 ± 0.22 |
| 18 | 25.6 ± 0.86 | 7.08 ± 0.22 | FL | 0.78 ± 0.07 | 62.2 ± 1.86 | 0.039 ± 0.003 | 65.9 ± 4.75 | 0.61 ± 0.15 |
| 19 | 34.7 ± 1.67 | 6.09 ± 0.47 | FL | 0.26 ± 0.07 | 55.3 ± 9.72 | 0.013 ± 0.003 | 50.4 ± 3.67 | 0.51 ± 0.04 |
| 20 | 36.4 ± 1.27 | 6.26 ± 0.35 | FL | 0.52 ± 0.08 | 64.2 ± 3.17 | 0.026 ± 0.003 | 51.7 ± 3.37 | 0.87 ± 0.90 |
| Soil Sample | SR ± DE (kg ha−1 d−1) | Classification | Nm ± DE (kg ha−1) | Classification |
|---|---|---|---|---|
| 1 | 0.18 ± 0.02 | No activity | 19.7 ± 1.23 | Low |
| 2 | 0.15 ± 0.03 | No activity | 18.7 ± 1.37 | Low |
| 3 | 0.11 ± 0.02 | No activity | 0.36 ± 0.17 | Very low |
| 4 | 0.14 ± 0.01 | No activity | 0.94 ± 0.36 | Very low |
| 5 | 0.10 ± 0.01 | No activity | 2.41 ± 0.52 | Very low |
| 6 | 0.09 ± 0.03 | No activity | 4.91 ± 0.46 | Very low |
| 7 | 0.08 ± 0.02 | No activity | 2.68 ± 0.47 | Very low |
| 8 | 0.09 ± 0.02 | No activity | 2.06 ± 0.13 | Very low |
| 9 | 0.05 ± 0.03 | No activity | 2.25 ± 1.21 | Very low |
| 10 | 0.13 ± 0.09 | No activity | 2.15 ± 0.69 | Very low |
| 11 | 0.16 ± 0.01 | No activity | 11.3 ± 0.32 | Very low |
| 12 | 0.19 ± 0.01 | No activity | 9.47 ± 0.34 | Very low |
| 13 | 0.20 ± 0.05 | No activity | 3.51 ± 0.48 | Very low |
| 14 | 0.14 ± 0.02 | No activity | 2.67 ± 0.35 | Very low |
| 15 | 0.08 ± 0.04 | No activity | 5.86 ± 0.55 | Very low |
| 16 | 0.18 ± 0.01 | No activity | 5.13 ± 0.90 | Very low |
| 17 | 0.05 ± 0.02 | No activity | 3.89 ± 0.66 | Very low |
| 18 | 0.14 ± 0.01 | No activity | 7.79 ± 0.63 | Very low |
| 19 | 0.10 ± 0.01 | No activity | 2.37 ± 0.61 | Very low |
| 20 | 0.10 ± 0.009 | No activity | 3.95 ± 0.57 | Very low |
| Parameter | Moisture | pH | Sand | Clay | Silt | OM | N | P | AD | Nm | Respiration | M-1 | M-2 | M-3 | M-4 | |
|---|---|---|---|---|---|---|---|---|---|---|---|---|---|---|---|---|
| Correlation Coefficient | p-value | |||||||||||||||
| Moisture | 1.00 | 0.46 | 0.64 | 0.60 | 0.95 | 0.91 | 0.91 | 0.62 | 0.38 | 0.77 | 0.05 | 0.15 | 0.50 | 0.00 | 0.74 | |
| pH | −0.10 | 1.00 | 0.41 | 0.61 | 0.35 | 0.19 | 0.19 | 0.30 | 0.65 | 0.14 | 0.53 | 0.62 | 0.51 | 0.09 | 0.00 | |
| Sand | 0.06 | 0.11 | 1.00 | 0.86 | 0.00 | 0.09 | 0.09 | 0.15 | 0.12 | 0.08 | 0.62 | 0.71 | 0.78 | 0.79 | 0.05 | |
| Clay | 0.07 | 0.07 | −0.02 | 1.00 | 0.00 | 0.21 | 0.21 | 0.50 | 0.00 | 0.09 | 0.06 | 0.86 | 0.26 | 0.43 | 0.91 | |
| Silt | −0.01 | −0.13 | −0.59 | −0.74 | 1.00 | 0.91 | 0.91 | 0.29 | 0.20 | 0.90 | 0.41 | 0.36 | 0.51 | 0.51 | 0.11 | |
| OM | 0.01 | 0.18 | −0.22 | 0.17 | 0.01 | 1.00 | 0.00 | 0.04 | 0.01 | 0.00 | 0.01 | 0.41 | 0.47 | 0.66 | 0.38 | |
| N | 0.01 | 0.18 | −0.22 | 0.17 | 0.01 | 1.00 | 1.00 | 0.04 | 0.01 | 0.00 | 0.01 | 0.41 | 0.47 | 0.66 | 0.38 | |
| P | −0.07 | 0.14 | −0.19 | −0.09 | 0.14 | 0.28 | 0.28 | 1.00 | 0.99 | 0.02 | 0.30 | 0.77 | 0.31 | 0.38 | 0.12 | |
| AD | −0.12 | −0.06 | −0.20 | 0.39 | −0.17 | −0.33 | −0.33 | 0.00 | 1.00 | 0.09 | 0.95 | 0.87 | 0.33 | 0.99 | 0.62 | |
| Nm | 0.04 | 0.20 | −0.23 | 0.23 | −0.02 | 0.98 | 0.98 | 0.30 | −0.23 | 1.00 | 0.00 | 0.41 | 0.46 | 0.74 | 0.35 | |
| Respiration | 0.26 | −0.08 | −0.07 | 0.25 | −0.11 | 0.35 | 0.35 | 0.14 | −0.01 | 0.40 | 1.00 | 0.35 | 0.46 | 0.91 | 0.79 | |
| M-1 | −0.19 | −0.07 | 0.05 | −0.02 | −0.12 | −0.11 | −0.11 | −0.04 | −0.02 | −0.11 | 0.13 | 1.00 | 0.01 | 0.01 | 0.24 | |
| M-2 | −0.09 | 0.09 | 0.04 | 0.15 | −0.09 | 0.10 | 0.10 | 0.14 | 0.13 | 0.10 | −0.10 | −0.36 | 1.00 | 0.00 | 0.10 | |
| M-3 | 0.39 | 0.22 | 0.04 | −0.11 | 0.09 | −0.06 | −0.06 | 0.12 | 0.00 | −0.04 | −0.02 | −0.32 | −0.45 | 1.00 | 0.14 | |
| M-4 | −0.04 | −0.42 | −0.26 | −0.02 | 0.21 | 0.12 | 0.12 | −0.21 | −0.07 | 0.12 | 0.04 | −0.16 | −0.22 | −0.19 | 1.00 | |
Disclaimer/Publisher’s Note: The statements, opinions and data contained in all publications are solely those of the individual author(s) and contributor(s) and not of MDPI and/or the editor(s). MDPI and/or the editor(s) disclaim responsibility for any injury to people or property resulting from any ideas, methods, instructions or products referred to in the content. |
© 2025 by the authors. Licensee MDPI, Basel, Switzerland. This article is an open access article distributed under the terms and conditions of the Creative Commons Attribution (CC BY) license (https://creativecommons.org/licenses/by/4.0/).
Share and Cite
Martínez Mera, E.; Torregroza-Espinosa, A.C.; De la Parra-Guerra, A.C.; Durán-Castiblanco, M.; Zapata-Herazo, W.; Rodríguez-Rebolledo, J.S.; Zabala-Sierra, F.; Alvarez, D.A.B. Soil Fungal Activity and Microbial Response to Wildfire in a Dry Tropical Forest of Northern Colombia. Diversity 2025, 17, 546. https://doi.org/10.3390/d17080546
Martínez Mera E, Torregroza-Espinosa AC, De la Parra-Guerra AC, Durán-Castiblanco M, Zapata-Herazo W, Rodríguez-Rebolledo JS, Zabala-Sierra F, Alvarez DAB. Soil Fungal Activity and Microbial Response to Wildfire in a Dry Tropical Forest of Northern Colombia. Diversity. 2025; 17(8):546. https://doi.org/10.3390/d17080546
Chicago/Turabian StyleMartínez Mera, Eliana, Ana Carolina Torregroza-Espinosa, Ana Cristina De la Parra-Guerra, Marielena Durán-Castiblanco, William Zapata-Herazo, Juan Sebastián Rodríguez-Rebolledo, Fernán Zabala-Sierra, and David Alejandro Blanco Alvarez. 2025. "Soil Fungal Activity and Microbial Response to Wildfire in a Dry Tropical Forest of Northern Colombia" Diversity 17, no. 8: 546. https://doi.org/10.3390/d17080546
APA StyleMartínez Mera, E., Torregroza-Espinosa, A. C., De la Parra-Guerra, A. C., Durán-Castiblanco, M., Zapata-Herazo, W., Rodríguez-Rebolledo, J. S., Zabala-Sierra, F., & Alvarez, D. A. B. (2025). Soil Fungal Activity and Microbial Response to Wildfire in a Dry Tropical Forest of Northern Colombia. Diversity, 17(8), 546. https://doi.org/10.3390/d17080546

